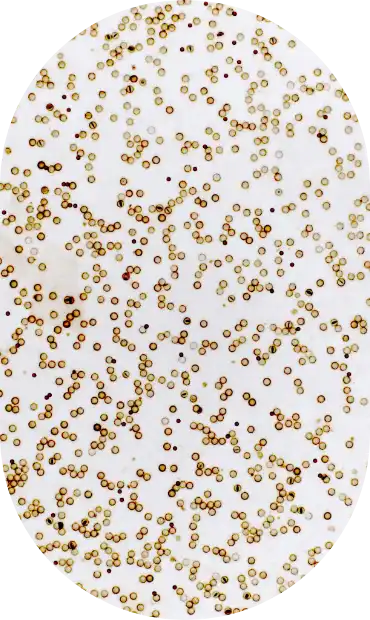
img hero team 01

We Need
Your Help
Finding the optimal analytic sensitivity set points for each important IHC assay is a daunting task because there are so many. We can certainly use help:
- Ideas about experimental design for additional IHC stains
- Pathologists with sub-specialty expertise for reading TMAs and data analysis
- Laboratories capable of creating TMAs